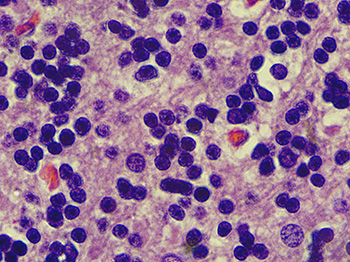
100x motic panthera lens ovary 100x motic panthera lens ovary

Microscope Image Comparison: ZEISS Primostar versus Motic Panthera
Nov 17th 2024
Recently, we looked at images on two different microscope systems: the ZEISS Primostar 3 and the Motic Panthera. We wanted to compare the images captured with both of these microscopes.
For both microscopes, the same digital camera was used to capture the images, a 5 megapixel microscope camera (the DCM5.3). Images displayed were captured with a 100x objective lens. For the ZEISS Primostar 3, the Zeiss iPlan Achromat 100x Objective was used. The Motic UC Plan Achromat 100x objective lens was used on the Motic Panthera microscope.
We found that the images taken with the ZEISS Primostar 3 and the Motic Panthera microscopes were comparable, and you can see for yourself in the table below.
| Zeiss Primostar 3 | Motic Panthera | |
![]() |
![]() |
|
![]() |
![]() |
|
![]() |
![]() |
|
![]() |
![]() |